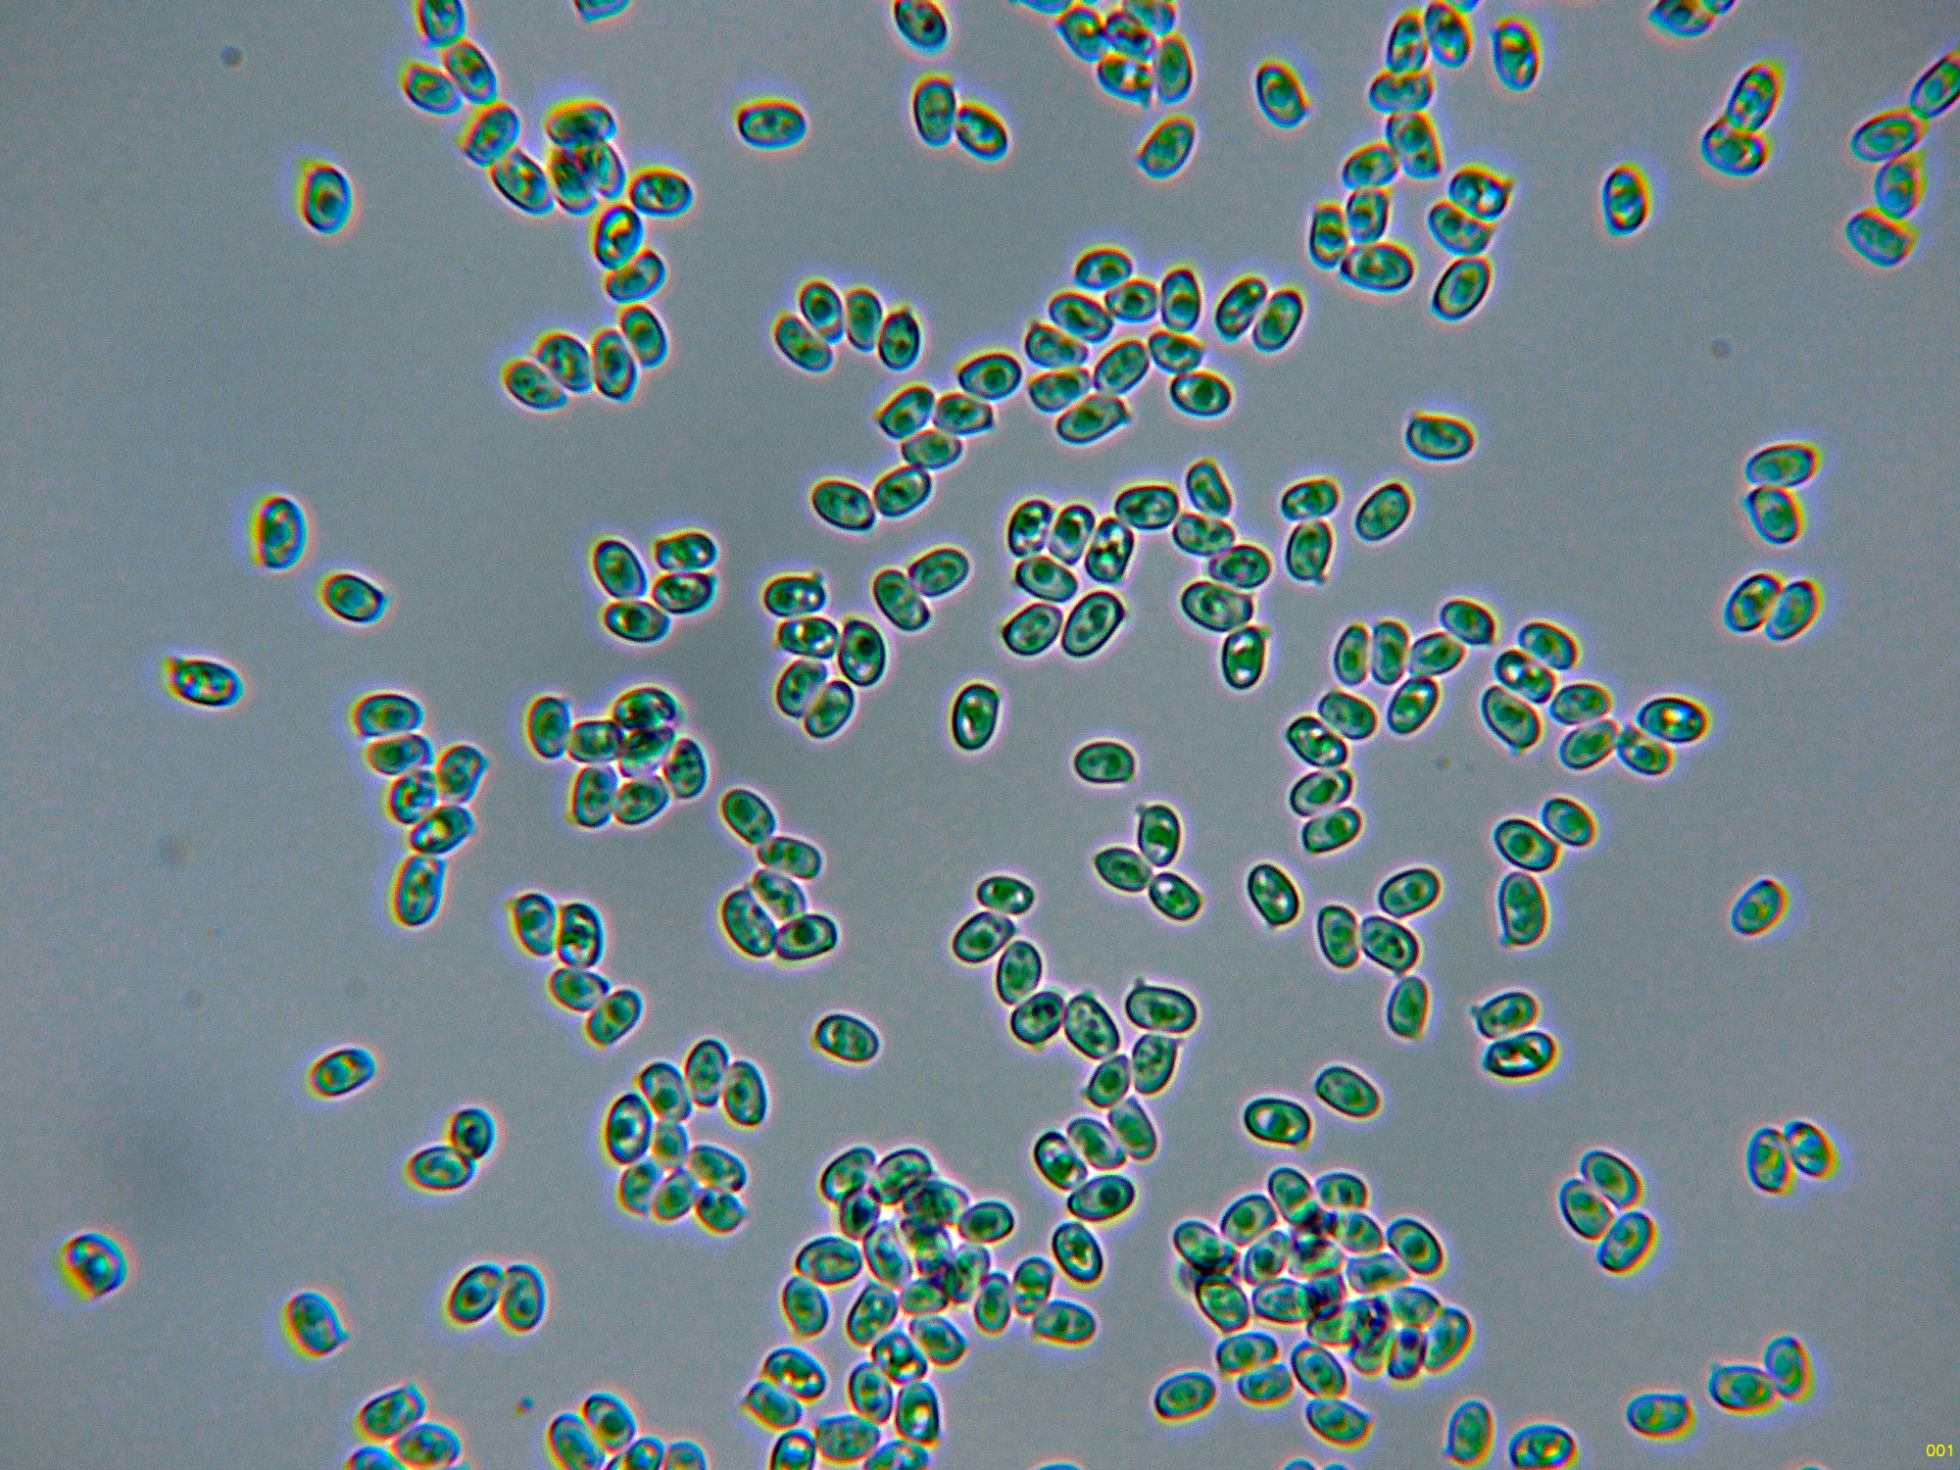
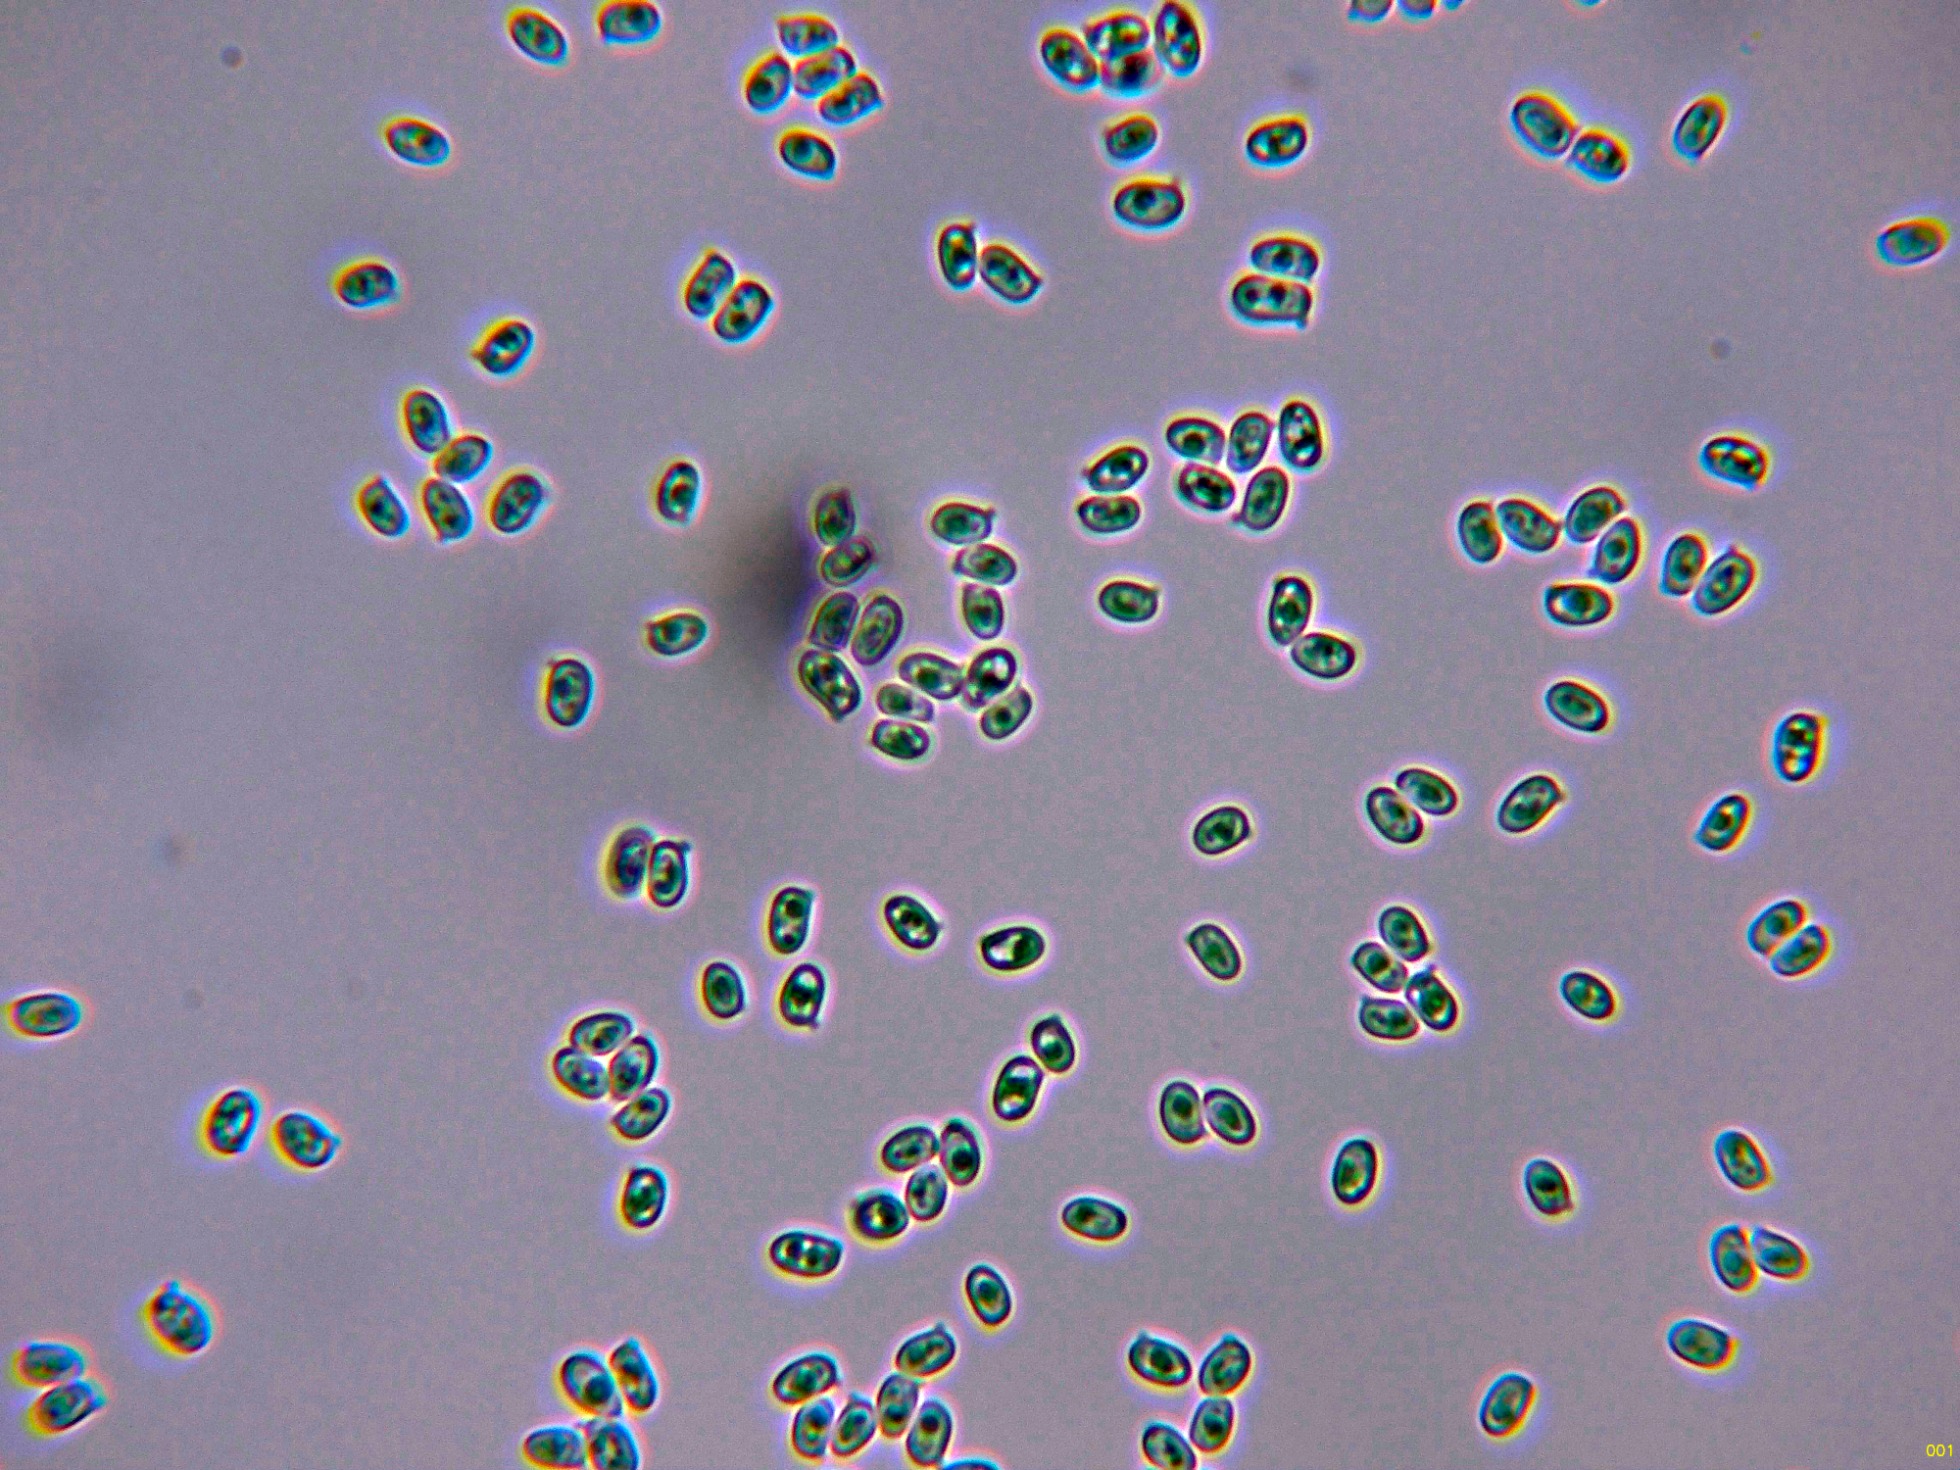

- Foro
- Foros sobre Micología de fungipedia
- Microscopía
- En agradecimiento a los Fungimasters: Echinoderma cf. carinii (Bres.) Bon
 En agradecimiento a los Fungimasters: Echinoderma cf. carinii (Bres.) Bon
En agradecimiento a los Fungimasters: Echinoderma cf. carinii (Bres.) Bon
- Josep Torres
-
 Autor del tema
Autor del tema
- Fuera de línea
- Moderador
-

Menos
Más
- Mensajes: 8746
- Gracias recibidas: 8379
2 años 3 meses antes #109694
por Josep Torres
En agradecimiento a los Fungimasters: Echinoderma cf. carinii (Bres.) Bon Publicado por Josep Torres
Hola a tod@s.
Un par de Lepiotas que me mandaron los Fungimasters, que venían dentro del mismo envoltorio y que por este detalle consideré que se trataba de lo mismo y saqué la imágen de las dos juntas.
Empezamos con la de mayor tamaño.
Echinoderma cf. carinii (Bres.) Bon
Syn: Lepiota carinii
El sombrero de la Lepiota de mayor tamaño superaba los 4 cm.
En una ampliación del centro del sombrero, se aprecian unas escamas piramidales que son típicas del género Echinoderma.
Detalle del pie y láminas.
La suprapellis en agua, con hifas cilíndricas y con tabiques cortos.
Hifas de la suprapellis en solución de Rojo Congo, con algunas hifas globosas, este detalle típico del género Echinoderma.
Arista laminar sin prácticamente elementos distintos de los basidios o basidiolos, la ausencia de cistidios se considera bastante habitual dentro del género, ya que estos cistidios pueden o no estar presentes.
Los basidios de la cara laminar.
Y ya las esporas obtenidas por esporulación natural y en agua:
Estas esporas en agua con unas medidas de:
(4) 4.1 - 4.8 (5.4) × (2.5) 2.6 - 3.1 (3.3) µm
Q = (1.4) 1.5 - 1.8 (1.9) ; N = 40
Me = 4.5 × 2.8 µm ; Qe = 1.6
Especie con unas medidas esporales muy parecidas a sus congéneres, la Echinoderma calcicola y la Echinoderma echinacea, ambas con escamas que cubren el sombrero en su totalidad y además estas escamas presentes en la superficie del pie, también muy parecida a la Echinoderma pseudoasperula, esta última con un tamaño menor, de solo hasta 2,5 cm.
En este estudio me quedan algunas dudas por la morfología de la pileipellis, entiendo que en mis muestras al ejercer demasiada presión eclosionaron y aunque apunta a la Echinoderma carinii propuesta, no pude observar con claridad sus características, por lo que no descarto probar de nuevo en el futuro con el exsiccata, de ahí lo de "cf".
Vamos con la Lepiota de menor tamaño.
Lepiota brunneoincarnata Chodat & C. Martín
Suprapellis en agua a 400 aumentos, con hifas cilíndricas alargadas, y con terminaciones redondeadas.
Queilocistidios muy abundantes que dejan prácticamente estéril la arista laminar.
Basidios de la cara laminar.
Esporas libres observadas en las muestras preparadas.
Estas esporas libres con unas medidas de:
(7.1) 7.7 - 9 (9.8) × (4.3) 4.5 - 5.2 (5.4) µm
Q = 1.6 - 1.87 (1.9) ; N = 30
Me = 8.3 × 4.8 µm ; Qe = 1.7
Evidentemente estamos ante dos especies completamente distintas.
Saludos cordiales,
Un par de Lepiotas que me mandaron los Fungimasters, que venían dentro del mismo envoltorio y que por este detalle consideré que se trataba de lo mismo y saqué la imágen de las dos juntas.
Empezamos con la de mayor tamaño.
Echinoderma cf. carinii (Bres.) Bon
Syn: Lepiota carinii
El sombrero de la Lepiota de mayor tamaño superaba los 4 cm.
En una ampliación del centro del sombrero, se aprecian unas escamas piramidales que son típicas del género Echinoderma.
Detalle del pie y láminas.
La suprapellis en agua, con hifas cilíndricas y con tabiques cortos.
Hifas de la suprapellis en solución de Rojo Congo, con algunas hifas globosas, este detalle típico del género Echinoderma.
Arista laminar sin prácticamente elementos distintos de los basidios o basidiolos, la ausencia de cistidios se considera bastante habitual dentro del género, ya que estos cistidios pueden o no estar presentes.
Los basidios de la cara laminar.
Y ya las esporas obtenidas por esporulación natural y en agua:
Estas esporas en agua con unas medidas de:
(4) 4.1 - 4.8 (5.4) × (2.5) 2.6 - 3.1 (3.3) µm
Q = (1.4) 1.5 - 1.8 (1.9) ; N = 40
Me = 4.5 × 2.8 µm ; Qe = 1.6
Especie con unas medidas esporales muy parecidas a sus congéneres, la Echinoderma calcicola y la Echinoderma echinacea, ambas con escamas que cubren el sombrero en su totalidad y además estas escamas presentes en la superficie del pie, también muy parecida a la Echinoderma pseudoasperula, esta última con un tamaño menor, de solo hasta 2,5 cm.
En este estudio me quedan algunas dudas por la morfología de la pileipellis, entiendo que en mis muestras al ejercer demasiada presión eclosionaron y aunque apunta a la Echinoderma carinii propuesta, no pude observar con claridad sus características, por lo que no descarto probar de nuevo en el futuro con el exsiccata, de ahí lo de "cf".
Vamos con la Lepiota de menor tamaño.
Lepiota brunneoincarnata Chodat & C. Martín
Suprapellis en agua a 400 aumentos, con hifas cilíndricas alargadas, y con terminaciones redondeadas.
Queilocistidios muy abundantes que dejan prácticamente estéril la arista laminar.
Basidios de la cara laminar.
Esporas libres observadas en las muestras preparadas.
Estas esporas libres con unas medidas de:
(7.1) 7.7 - 9 (9.8) × (4.3) 4.5 - 5.2 (5.4) µm
Q = 1.6 - 1.87 (1.9) ; N = 30
Me = 8.3 × 4.8 µm ; Qe = 1.7
Evidentemente estamos ante dos especies completamente distintas.
Saludos cordiales,
Adjuntos:
El siguiente usuario dijo gracias: Juan Andrés Román, Juan
Por favor, Identificarse para unirse a la conversación.
- Javi Calvo
-

- Fuera de línea
- Spammer
-

Menos
Más
- Mensajes: 7009
- Gracias recibidas: 2955
2 años 3 meses antes #109695
por Javi Calvo
Respuesta de Javi Calvo sobre el tema En agradecimiento a los Fungimasters: Echinoderma cf. carinii (Bres.) Bon
Gracias Josep, que torpeza la mía, mira que meter juntas dos especies distintas. Lo curioso es que salían juntas una al lado de la otra. De Lepiota brunneoincarnata, especie mortal, había gran cantidad, he encontrado recolectas en internet de Echinoderma carinii con un hábitat idéntico a nuestra recolecta, bajo Cedrus atlántica. Un saludo
Por favor, Identificarse para unirse a la conversación.
- Josep Torres
-
 Autor del tema
Autor del tema
- Fuera de línea
- Moderador
-

Menos
Más
- Mensajes: 8746
- Gracias recibidas: 8379
2 años 3 meses antes #109696
por Josep Torres
Respuesta de Josep Torres sobre el tema En agradecimiento a los Fungimasters: Echinoderma cf. carinii (Bres.) Bon
Gracias Javi, más a favor pues que se trate de la Echinoderma carinii propuesta.
Saludos.
Saludos.
El siguiente usuario dijo gracias: Juan Andrés Román, Juan
Por favor, Identificarse para unirse a la conversación.
- Juan
-

- Fuera de línea
- Moderador
-

Menos
Más
- Mensajes: 553
- Gracias recibidas: 608
2 años 1 mes antes #109828
por Juan
Respuesta de Juan sobre el tema En agradecimiento a los Fungimasters: Echinoderma cf. carinii (Bres.) Bon
El siguiente usuario dijo gracias: Josep Torres
Por favor, Identificarse para unirse a la conversación.
- Josep Torres
-
 Autor del tema
Autor del tema
- Fuera de línea
- Moderador
-

Menos
Más
- Mensajes: 8746
- Gracias recibidas: 8379
2 años 1 mes antes #109857
por Josep Torres
Respuesta de Josep Torres sobre el tema En agradecimiento a los Fungimasters: Echinoderma cf. carinii (Bres.) Bon
El siguiente usuario dijo gracias: Juan
Por favor, Identificarse para unirse a la conversación.
- Foro
- Foros sobre Micología de fungipedia
- Microscopía
- En agradecimiento a los Fungimasters: Echinoderma cf. carinii (Bres.) Bon
Tiempo de carga de la página: 0.055 segundos

Foro de micología